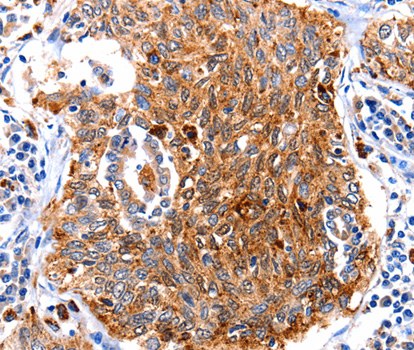
product-image-AAA302678_IHC13.jpg
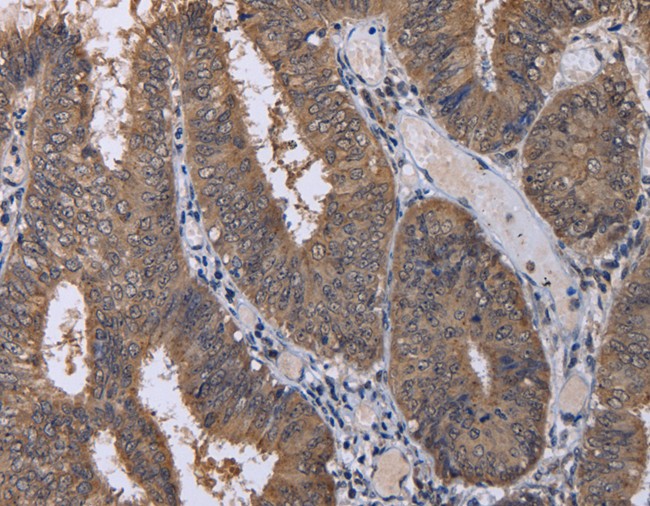
product-image-AAA167569_IHC11.jpg

Rabbit anti-Human, Mouse Cullin-3 Polyclonal Antibody | anti-CUL3 antibody
Cullin-3 Antibody
FCM/FACS (Flow Cytometry)
(Flow cytometric analysis of SH-SY5Y cells with Cullin 3 antibody at 1/100 dilution (red) compared with an unlabelled control (cells without incubation with primary antibody; black). Alexa Fluor 488-conjugated goat anti-rabbit IgG was used as the secondary antibody.)
IHC (Immunohistochemisry)
(Immunohistochemical analysis of paraffin-embedded human placenta tissue using anti-Cullin-3 antibody. Counter stained with hematoxylin.)
IHC (Immunohiostchemistry)
(Immunohistochemical analysis of paraffin-embedded human kidney tissue using anti-Cullin-3 antibody. Counter stained with hematoxylin.)
WB (Western Blot)
(Western blot analysis of Cullin 3 on different lysates using anti-Cullin 3 antibody at 1/1, 000 dilution. Positive control�� Lane1: SH-SY5Y Lane2: 293T Lane3: Mouse testis tissue)
NCBI and Uniprot Product Information
Customer Reviews
Loading reviews...
Share Your Experience
Similar Products
Product Notes
The CUL3 cul3 (Catalog #AAA312103) is an Antibody produced from Rabbit and is intended for research purposes only. The product is available for immediate purchase. The Cullin-3 Antibody reacts with Human, Mouse and may cross-react with other species as described in the data sheet. AAA Biotech's Cullin-3 can be used in a range of immunoassay formats including, but not limited to, FCM/FACS (Flow Cytometry), IHC (Immunohistochemistry), WB (Western Blot). Researchers should empirically determine the suitability of the CUL3 cul3 for an application not listed in the data sheet. Researchers commonly develop new applications and it is an integral, important part of the investigative research process. It is sometimes possible for the material contained within the vial of "Cullin-3, Polyclonal Antibody" to become dispersed throughout the inside of the vial, particularly around the seal of said vial, during shipment and storage. We always suggest centrifuging these vials to consolidate all of the liquid away from the lid and to the bottom of the vial prior to opening. Please be advised that certain products may require dry ice for shipping and that, if this is the case, an additional dry ice fee may also be required.Precautions
All products in the AAA Biotech catalog are strictly for research-use only, and are absolutely not suitable for use in any sort of medical, therapeutic, prophylactic, in-vivo, or diagnostic capacity. By purchasing a product from AAA Biotech, you are explicitly certifying that said products will be properly tested and used in line with industry standard. AAA Biotech and its authorized distribution partners reserve the right to refuse to fulfill any order if we have any indication that a purchaser may be intending to use a product outside of our accepted criteria.Disclaimer
Though we do strive to guarantee the information represented in this datasheet, AAA Biotech cannot be held responsible for any oversights or imprecisions. AAA Biotech reserves the right to adjust any aspect of this datasheet at any time and without notice. It is the responsibility of the customer to inform AAA Biotech of any product performance issues observed or experienced within 30 days of receipt of said product. To see additional details on this or any of our other policies, please see our Terms & Conditions page.Item has been added to Shopping Cart
If you are ready to order, navigate to Shopping Cart and get ready to checkout.